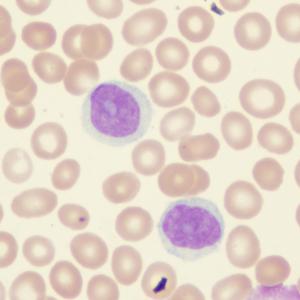

News & Updates
Filter by Specialty:

Mobile app captures symptoms, biometrics of bladder cancer patients after cystectomy
Patients with bladder cancer who underwent radical cystectomy may benefit from the use of smartphones and wearable technology to monitor their symptoms as well as biometric data, according to a recent study.
Mobile app captures symptoms, biometrics of bladder cancer patients after cystectomy
08 Mar 2023
CheckMate 274 follow up data boost nivolumab potential for high-risk bladder cancer
In the extended follow up of the phase III CheckMate 274 trial, nivolumab continued to show benefit for patients with muscle-invasive urothelial carcinoma (MIUC; bladder, ureter, or renal pelvis) who were at high risk for recurrence following bladder resection.
CheckMate 274 follow up data boost nivolumab potential for high-risk bladder cancer
08 Mar 2023
Post-treatment neutrophil, lymphocyte counts offer clues to Hodgkin’s lymphoma prognosis
For patients with Hodgkin’s lymphoma who have completed a first-line chemotherapy regimen that includes doxorubicin, bleomycin, vinblastine, and dacarbazine (ABVD), neutrophil and lymphocyte counts are predictive of disease prognosis, as reported in a study from Singapore.
Post-treatment neutrophil, lymphocyte counts offer clues to Hodgkin’s lymphoma prognosis
08 Mar 2023
Local plus systemic therapies improve survival in HCC
Combination therapy using yttrium 90 (Y90) radioembolization and sorafenib/nivolumab for patients with hepatocellular carcinoma (HCC), with hepatic vein (HV) or inferior vena cava (IVC) invasion, results in better outcomes, as indicated by increased response rates, overall survival (OS), and progression-free survival (PFS) benefits, a study has found.
Local plus systemic therapies improve survival in HCC
07 Mar 2023
Darolutamide-containing triplet regimen ups survival in mHSPC regardless of disease volume, risk
In a post hoc analysis of the phase III ARASENS study, the triplet regimen comprising darolutamide, androgen deprivation therapy (ADT), and docetaxel continued to show overall survival (OS) benefit for metastatic hormone-sensitive prostate cancer (mHSPC) irrespective of disease volume and risk.
Darolutamide-containing triplet regimen ups survival in mHSPC regardless of disease volume, risk
06 Mar 2023
Rucaparib improves rPFS vs docetaxel or 2nd-generation ARPI in BRCA-mutated mCRPC
Rucaparib significantly improves radiographic progression-free survival (rPFS) vs physician’s choice of docetaxel, abiraterone acetate or enzalutamide in patients with metastatic castration-resistant prostate cancer (mCRPC) harbouring BRCA alterations whose disease has progressed after treatment with a second-generation androgen-receptor pathway inhibitor (ARPI), results of the phase III TRITON3 trial have shown.
Rucaparib improves rPFS vs docetaxel or 2nd-generation ARPI in BRCA-mutated mCRPC
06 Mar 2023
Neoadjuvant immunotherapy delivers in cisplatin-ineligible bladder cancer
The use of pembrolizumab in the neoadjuvant setting appears to be associated with a higher rate of downstaging and a survival advantage among patients with muscle-invasive bladder cancer (MIBC) who are ineligible for cisplatin-based neoadjuvant chemotherapy, according to a study presented at this year’s ASCO Genitourinary Cancers Symposium.
Neoadjuvant immunotherapy delivers in cisplatin-ineligible bladder cancer
03 Mar 2023
Nivolumab plus cabozantinib superior to sunitinib in renal cell carcinoma
First-line treatment of advanced renal cell carcinoma (aRCC) with nivolumab plus cabozantinib (N+C) results in sustained survival and response benefits at 3 years minimum follow-up, which is consistent with previous follow-ups, according to a study presented at the 2023 ASCO GU Cancers Symposium.